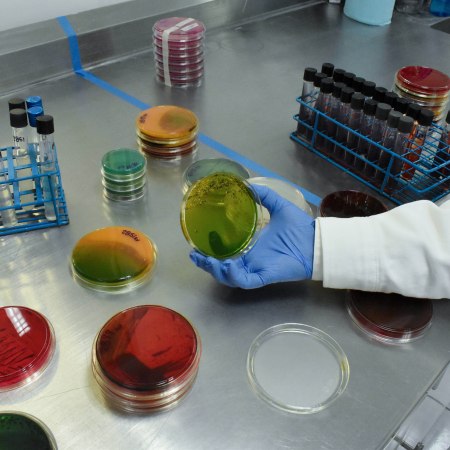

Categoría: SALUD


En marcha, Modelo de Atención a la Salud Mental y Adicciones en México

Personas con VIH reciben tratamiento, con igual expectativa de vida de quienes no tienen infección

México impulsa acciones para evitar nuevas infecciones de VIH

Secretaría de Salud se suma a los 16 días de activismo contra la violencia de género

Especialistas amplían conocimientos sobre discapacidad en personas adultas mayores

El 1º de diciembre se conmemora el Día Mundial del Sida

Congreso de prevención de discapacidad en adultos mayores
Semana Mundial de Concientización sobre la Resistencia a los Antimicrobianos

